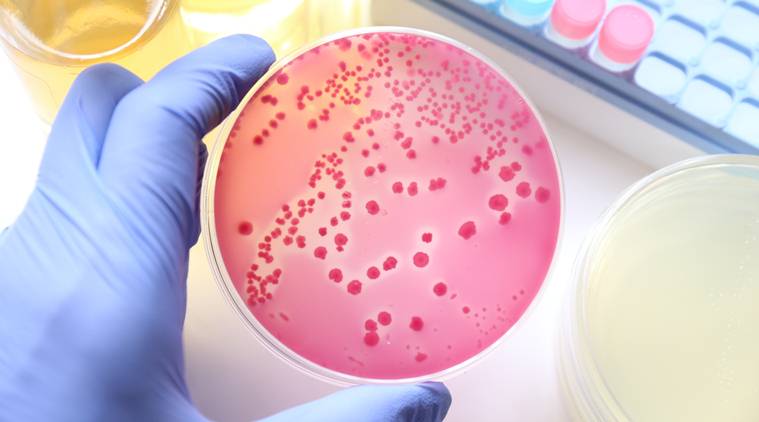

India Inc raises over Rs 36,000 crore via QIP in April-September
NEW DELHI: Indian firms mobilised over Rs 36,000 crore through issuance of shares to institutional investors during April-September period of the current fiscal, a 13-fold rise from the year-ago period.As per the latest data available with the Securities and Exchange Board of India ( Sebi ), capital garnered by the listed companies through the Qualified Institutional Placement ( QIP ) route stood at Rs 36,653 crore in the first six months of 2017-18.In comparison, firms had mopped-up Rs 2,818 crore in April-September period of 2016-17.The capital garnered by the listed companies in the first six months of 2017-18 is also four times the total amount raised in the entire 2016-17, which stood at Rs 8,464 crore.The funds have been mobilised for business expansion, refinancing of debt, working capital requirements and other general corporate purposes.QIP is an alternative mode of resource raising available for listed companies to raise funds from the domestic market In terms of numbers, 16 issues were witnessed in the first six months of the current fiscal as compared to 9 during the same period of the previous financial year.
Source: Economic Times November 05, 2017 09:56 UTC